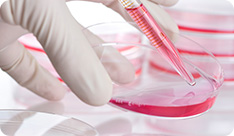

9104 | Dr. Vishwanath V. M. |  | | LANGUAGE AND SCRIPT EVOLUTION IN MEDIEVAL INDIA: UNVEILING THE HISTORICAL TAPESTRY |
| |
|
9078 | Dr. Ishtiaque Ahmed |  | | AN ANALYSIS OF THE ROLE OF LIC TOWARDS CORPORATE SOCIAL RESPONSIBILITY |
| |
|
9008 | Irshad M. B. |  | | CITY STRUCTURE AND URBANIZATION OF BANGALORE |
| |
|
8920 | डाॅ. रेखा मि. गुल्हाने |  | | नागपूर महानगरपालिकेने नगरवासींयांकरीता केलेल्या विविध कार्यांचे मूल्यमापनः एक अध्ययन |
| |
|
8897 | Dr. Basawaraj K. Ashtagi |  | | WOMEN IN PRINT JOURNALIST IN MEDIA |
| |
|
8855 | विभा बाला, डाॅ. सरोजनी देवी |  | | आधुनिक समाज में तलाक के बढ़ते समस्या का विश्लेषणात्मक अध्ययन |
| |
|
8843 | प्रा.डाॅ. विश्वनाथ पवार |  | | संत तुकारामांकडून ढोंगी साधुंचा पर्दाफाश |
| |
|
8837 | सुनीता चौहान |  | | भारतीय राजनीति में चुनाव सुधार |
| |
|
8822 | Amit Prakash |  | | STUDIES ON MINKOWSKI SPACE FOR SOLUTION OF EINSTEIN EQUATIONS |
| |
|
8803 | Prof. K. Shiva Shankar |  | | CHANGING TRENDS IN ADVERTISING : A CRITICAL ANALYSIS OF INDIAN ADVERTISING |
| |
|
8645 | Prof. Dhere S.R. |  | | A STUDY OF INTERNATIONAL ACCOUNTING STANDARD AND INDIAN ACCOUNTING STANDARD |
| |
|
8554 | Dr. Amit Kumar Srivastava |  | | EPOCHS OF THE UNIVERSE WITH EXACT INHOMOGENEOUS SOLUTIONS |
| |
|
7832 | Dr. Vinay B. Patil |  | | USE OF LIBRARY BY FACULTY MEMBERS: A STUDY OF NMU REGION |
| |
|
7664 | प्रा.डॉ. आय. जे. तांबोळी |  | | 21 व्या शतकातील मराठी भाषा |
| |
|
6642 | Kumara Naik |  | | GANDHI AN DECENTRALISED SYSTEM AND RURAL DEVELOPMENT |
| |
|
6492 | Keerthishree R Doddamani , Mallikarjun Hangarge |  | | LIBRARY MANAGEMENT SYSTEM |
| |
|
6447 | गोपाल सिंह नयाल , ए दीक्षा खम्पा, ए शान्ति नयाल |  | | ‘‘अल्मोड़ा जनपद के किशोर जनसंख्या का पर्यावरणीय ज्ञान एवं पर्यावरणीय जागरूकता का तुलनात्मक अध्ययन’’ |
| |
|
6136 | Shivaganga .U. Bilagundi |  | | A crticicism of Dr. D.V. Halligudi’s novel “Anubandhadad Sambhanda” |
| |
|
5967 | गजानन जाधव |  | | कैलास दौंड यांच्या कवितेतील बदलते ग्रामीण वास्तव |
| |
|
5947 | M. P. Gaur |  | | SPORTS TOURISM AS A KEY FACTOR TO MAKE IN INDIA |
| |
|
5936 | Satpal Kaur |  | | PERSONALITY ASSESSMENTTRAITS : AN OVERVIEW |
| |
|
5903 | Ashok Vithoba Kodalkar |  | | HISTORY OF SOLAPUR |
| |
|
5896 | Sanchayita Roy |  | | HISTORICAL METHOD IN RESEARCH : A CONCEPTUAL REVIEW |
| |
|
5587 | रेनु बाला D/O श्री हंसराज |  | | रूपदेवगुण के साहित्य में मनोवृत्तियों का सूक्ष्म विश्लेषण |
| |
|
5586 | राजविन्द्र W/O श्री रणजीत सिंह |  | | संत मलूकदास के काव्य में दार्शनिक चिंतन |
| |
|
5584 | मीनू रानी W/O श्री रणवीर सिंह मूण्ड |  | | आचार्य कवि देव का ॠतू-वर्णन |
| |
|
5583 | दीपवाली देवी W/O श्री फूल सिंह |  | | यशपाल शर्मा कृत उपन्यास 'उडान' में व्यक्त समाज |
| |
|
5582 | भागीरथ |  | | यशपाल की कहानियों का कलागत अध्ययन |
| |
|
5576 | S. D. Kuduk |  | | THE URBAN CO-OPERATIVE BANKS, HISTORICAL PERSPECTIVE AND REVIEW BY THE MAJOR COMMITTEESA |
| |
|
5378 | भुवनेश्वर टेंभरे |  | | पर्यटन एवं विकास : पेंच राष्ट्रीय उद्यान के संदर्भ में भौगोलिक अध्ययन |
| |
|
5356 | Daniel Penkar |  | | “PERFORMANCE OF SHIVSHAKTI URBAN CO-OPERATIVE BANK LTD. OF BARSHI” |
| |
|
5349 | मंजुला पाण्डेय |  | | काव्य भाषा – सामान्य रूप और प्रभाव (विशेष संदर्भ मध्यकालीन काव्य भाषा) |
| |
|
5324 | K. JEMILA |  | | IDENTIFYING THE MOST PREFERRED BRAND OF WASHING MACHINE AND ASSOCIATED FACTORS – A SURVEY |
| |
|
5313 | V. Kumar , V. Sareen , V. Khatri and S. Sareen |  | | RECENT USES OF 2,4,6-TRICHLORO-1,3,5- TRIAZINES AND ITS DERIVATIVES |
| |
|
5312 | सुनीता त्रिपाठी |  | | धूमिल के काव्य में उच्च, मध्य एवं निम्न वर्ग का आर्थिक संघर्ष |
| |
|
5311 | Vijayalaxmi B. Patil , Laxmi Devi B. Harasoor |  | | REPRODUCTIVE HEALTH OF RURAL WOMEN IN GULBARGA DISTRICT |
| |
|
5309 | Godavari B. Patil , Laxmi Devi B. Harasoor |  | | WORKING WIVES AND HOUSEWIVES IN GULBARGA CITY:A SOCIOLOGICAL ANALYSIS |
| |
|
5308 | ललिता रानी |  | | समकालीन कविता में कवियों का अजनबीपन |
| |
|
5306 | Bhurelal Patidar , Dinesh Kumar Gupta |  | | SERVICES MARKETING IN INDIA: EMERGING OPPORTUNITIES AND CHALLENGES |
| |
|
5305 | Radhika |  | | LOTUS – THE NATIONAL FLOWER OF INDIA: A MYSTICAL SYMBOL IN INDIAN TRADITION, ART AND CULTURE |
| |
|
5304 | Amardeep D. Jadhav |  | | INCLUSIVE EDUCATION IN THE INDIAN CONTEXT |
| |
|
5303 | राज पॉल |  | | हिंदी समाचारपत्रों में ‘पेड़ न्यूज’ : प्रकरण अध्ययन |
| |
|
5302 | P. Saumini , A. K. Polson |  | | MANIFESTATIONS OF CONFLICT AND ETERNAL QUEST FOR FREEDOM IN AMITAV GHOSH’S THE SHADOW LINES-A GLANCE |
| |
|
5301 | Antoinette Sujatha , J .Kausalya |  | | EFFECT OF LINGUISTIC ENVIRONMENT ON ACHIEVEMENT IN ENGLISH - A SURVEY |
| |
|
5300 | Fred Felix |  | | INCREASING AGING POPULATION-A GLOBAL PHENOMENON-A REMEDY TO MEET THE FINANCIAL GAP CAUSED |
| |
|
5299 | Isakov J. Ya. |  | | CREDITING OF SERVICE INDUSTRY IN DEVELOPING COUNTRIES: UZBEKISTAN& EXPERIENCE |
| |
|
5287 | Kumar Ashish , Devyani Shekhar |  | | SANCTITY OF USE OF THIRD DEGREE TORTURE DURING INVESTIGATION |
| |
|
5281 | Santoshi Thimmareddy , K. S. Mailpatil |  | | A STUDY ON SPORTS PARTICIPATION IN FEMALE STUDENTS OF HYDERABAD KARNATAKA |
| |
|
5275 | Shrikant Yelegaonkar |  | | RESOURCE SCARCITY AND POLITICAL CONFLICT |
| |
|
5263 | Ven. Ashin Tayzaniya |  | | BUDDHIST POLITICAL PRINCIPLES AND DUTIES OF KING AGAINST DICTATORSHIP IN THE THERAVADA BUDDHIST POINT OF VIEW |
| |
|
5262 | Thaw Bi Ta |  | | THE TWO GREAT GUARDIANS OFTHE WORLD IN THERAVADA BUDDHISM (HIRI AND OTTAPPA) |
| |
|
5261 | Chandadhika , V. Chadrasekar |  | | THE WAY OF THE ULTIMATE GOAL (NIBBANA) IN MANGALA SUTTA |
| |
|
5260 | Madhuri P. Kamble , Agnihotri G. M. |  | | MANAGEMENT OF PROMOTION OF ENTREPRENEURSHIP PROGRAMME IN AN EDUCATIONAL INSTITUITIONS. |
| |
|
5259 | राजविन्द्र |  | | संत मलूकदास के काव्य में दार्शनिक चिंतन |
| |
|
5258 | रेनु बाला |  | | रूपदेवगुण के साहित्य में मनोवृतियों का सूक्ष्म विश्लेषण |
| |
|
5257 | दीपवली देवी |  | | यशपाल शर्मा कृत उपन्यास ‘उडान’ में व्यक्त समाज |
| |
|
5256 | दत्तात्रय नानासाहेब फुके |  | | रस सिद्धान्त : एक विवेचन |
| |
|
5240 | Santosh Kumar and Sandeep B.H. |  | | TO STUDY THE DEATH ANXIETY AND LOCUS OF CONTROL AMONG THE HIV/ AIDS PATIENTS. |
| |
|
5239 | S. V. Sharma |  | | A STUDY OF STUDENTS’ PERFORMANCE ABOUT THE SUBJECT CONTENT IN VIEW OF THINKING SKILLS APPROACH |
| |
|
5238 | Rajendra Kumbhar |  | | DYING COTTON AND SILK WITH SOME NATURAL DYES USING SINGLE POT METHOD CONTAINING ENZYMES |
| |
|
5237 | Prashant Thote and L. Mathew |  | | AN ANALYSIS ON IMPACT OF INTERPERSONAL SKILL ON ATTITUDE OF SCHOOL LEADERSHIP |
| |
|
5235 | M. Ramesh and M.Mohamed Nazar |  | | EARLY KAVAL (POLICE) SYSTEM IN TINNEVELLY |
| |
|
5234 | Jyoti Rani |  | | INFLATION AND ECONOMIC GROWTH IN INDIA |
| |
|
5233 | Gazala Bhoje |  | | FOREIGN UNIVERSITIES IN INDIA |
| |
|
5232 | Birendra Kumar Tiwari |  | | LEGAL RECOGNITION OF DIGITAL SIGNATURE UNDER INFORMATION TECHNOLOGY ACT |
| |
|
5231 | Avisek Chaudhuri and Amiya Kumar Das |  | | WEB 2.0 TECHNOLOGIES IN MODERN LIBRARY AND INFORMATION SERVICES: A STUDY ABOUT THE NEW ERA OF LIBRARY 2.0 |
| |
|
5230 | Ashok Kumar Prabhu and Manjula B. Chincholi |  | | POLITICAL HISTORY OF KELADI DYNASTY |
| |
|
5228 | Salman Ahmad Khan , Syed Tariq Murtaza, PhD , Dr.Mohd.Imran , Dr.Mohd.Sharique , Taufiq Ahmad , Dr.Farkhunda Jabin , Ashish Kumar Katiyar , Shamshad Ahmad , Ravi Prakash Singh, Arshad Hussain Bhat , Raof Ahmad Bhat , Irshad Maqbool Malik , Showkat Ahmad Naikoo , Mohd Zakir , Mohd. Sabir , Iftikhar Ahmad , Sateesh Chandra, Lalita Kumari, Tasleem Khan , Sarver Ali ,Qamber Rizwan ,Intazar Ali and Vinay Kumar Singh |  | | CONSTRUCTION OF TRAINING LOG FOR WICKET KEEPER IN CRICKET |
| |
|
5227 | Mohd Zakir , Syed Tariq Murtaza, PhD , Dr.Mohd.Imran , Dr.Mohd.Sharique , Taufiq Ahmad , Dr.Farkhunda Jabin , Ashish Kumar Katiyar , Shamshad Ahmad , Ravi Prakash Singh, Arshad Hussain Bhat , Salman Ahmad Khan, Raof Ahmad Bhat , Irshad Maqbool Malik , Showkat Ahmad Naikoo , Mohd. Sabir , Iftikhar Ahmad , Sateesh Chandra, Lalita Kumari, Tasleem Khan , Sarver Ali , Qamber Rizwan , Intazar Ali and Vinay Kumar Singh |  | | TRAINING LOG TO DETERMINE SKILLS OF FIELDING IN CRICKET |
| |
|
5226 | Lalita Kumari , Syed Tariq Murtaza, PhD , Dr.Mohd.Imran , Dr.Mohd.Sharique , Taufiq Ahmad , Dr.Farkhunda Jabin , Ashish Kumar Katiyar , Shamshad Ahmad , Ravi Prakash Singh, Arshad Hussain Bhat , Salman Ahmad Khan, Raof Ahmad Bhat , Irshad Maqbool Malik , Showkat Ahmad Naikoo , Mohd Zakir , Mohd. Sabir , Iftikhar Ahmad , Sateesh Chandra, Tasleem Khan , Sarver Ali , Qamber Rizwan , Intazar Ali and Vinay Kumar Singh |  | | OBSERVATORY LOG FOR SPINNERS IN THE GAME OF CRICKET |
| |
|
5224 | Ajay M. Bhamare |  | | HOW EDUCATION AND TRAINING SKILLS AFFECT THE ECONOMY |
| |
|
5222 | संजय संभाजी लांडगे |  | | तेंडूलकरांच्या ‘घाशीराम कोतवाल’ मधील व्यक्तिदर्शन आणि आशय सौंदर्याचा विचार |
| |
|
5220 | Kumar Ashish and Devyani Shekhar |  | | SANCTITY OF USE OF THIRD DEGREE TORTURE DURING INVESTIGATION |
| |
|
5215 | शारदा बंडे |  | | भारतातील मोगल काळातील स्त्रियांची स्थिती |
| |
|
5214 | Poonam Suryal |  | | पद्मभूषण उस्ताद हाफिज आली खाँ साहब के सरोद वादन की विशिष्टता |
| |
|
5213 | शकील शेख |  | | ‘सागर’ यांच्या गझलांतील भावाविष्कार |
| |
|
5212 | मनीषा दुबे , गायत्री गोयल |  | | “ग्रामीण विकास की दिशा में कृषि एवं सेवा में कार्यरत महिलओं का योगदान – एक विश्लेषणात्मक अध्ययन”(छत्तीसगढ़ के रायपुर, जाँजगीरव- चाम्पा एवं कोरबा जिले के विशेष संदर्भ में) |
| |
|
5211 | राजेंद्र धाये |  | | हैद्राबाद मुक्तीसंग्राम आणि स्टेट कॉग्रेस |
| |
|
5210 | Vishal Narayan Shinde |  | | EFFICACY OF MIXED FUNGICIDE AGAINST TEN PATHOGENIC FUNGI OF LEAFY VEGETABLES |
| |
|
5209 | Subash S. Sannashiddannanavar |  | | LAND USE LAND COVER ANALYSIS OF HAVERI DISTRICT : USING REMOTE SENSING |
| |
|
5208 | Savita Sangwan |  | | ROLE OF FAMILY LIFE EDUCATION ON DECISION-MAKING ASPECT OF RURAL WOMEN |
| |
|
5207 | Sachin S. Huggi |  | | MODERNIZATION AND FAMILY LIFE : A SOCIOLOGICAL INQUIRY |
| |
|
5206 | Ritu Yadav |  | | ROLE OF BHAGAVAD GITA IN CURRENT BUSINESS ENVIRONMENT |
| |
|
5205 | R. S. Shikalgar |  | | A STUDY ON POPULATION GROWTH OF MAN RIVER BASIN IN MAHARASHTRA |
| |
|
5204 | R. Ravi , Manju S. |  | MENTAL HEALTH BETWEEN ARTS AND SCIENCE TEACHERS AT SCHOOL LEVEL – A COMPARATIVE STUDYnaltrexone information go vivitrol uk |
| |
|
5203 | Nandkishor N. Shinde , Dadasaheb S. Gajhans |  | | SHAPE ANALYSIS OF RURAL SETTLEMENT IN SOME REGION OF JALGAON DISTRICT |
| |
|
5202 | H. B. Kenchall |  | | A REMINISCENCE QUIT INDIA MOVEMENT |
| |
|
5200 | Devender Singh |  | | SIGNIFICANCE OF KOS MINAR (MILESTONE) IN MEDIEVAL PERIOD |
| |
|
5199 | D.M. Madari , Sheela I. Shekadar |  | | IMPACT OF IRRIGATION ON CROPPING PATTERN AND PRODUCTIVITY WITH SPECIAL REFERENCE TO VIJAPUR DISTRICT |
| |
|
5198 | Basudeb Roy Chaudhury , Shampa Mondal |  | | REQUIREMENT OF MID-DAY MEAL PROGRAMME FOR SECONDARY LEVEL (9-10 ) SCHOOL STUDENTS IN THE RURAL AREAS IN WEST BENGAL. |
| |
|
5194 | महेश कुमार रचियता |  | | गांधी एवं राजनीति का आध्यात्मिकरण |
| |
|
5192 | K. L. Kagade , V. P. Narkhede |  | | SOLVING FUZZY ASSIGNMENT PROBLEM WITH TRAPEZOIDAL FUZZY NUMBERS USING ROBUST RANKING AND ZERO SUFFIX METHOD |
| |
|
5191 | Kadam Santosh N. , Suryawanshi Santosh D. |  | | CONTEMPORARY ISSUE OF E-COMMERCE AND ITS IMPLICATIONS IN INDIAN ECONOMY |
| |
|
5188 | Mehvish Syed |  | | POWERLESS FEMALE FIGURES IN TWENTIETH CENTURY AMERICAN DRAMA |
| |
|
5180 | Kankana Baishya |  | | BUILDING A DIGITAL INSTITUTIONAL REPOSITORY IN INDIA: A STUDY |
| |
|
5179 | Ramzan S. Virani , Subodh N. Bansod |  | | STUDY OF WADERS DIVERSITY FROM SELECTED WATER BODIES OF YAVATMAL DISTRICT IN CENTRAL INDIA. |
| |
|
5177 | L.manju Bhargavi , Sandeep Kumar M. |  | | “A STUDY ON CONSUMER BEHAVIOUR TOWARDS MOBILE SERVICES” – A STUDY WITH REFERENCE TO SEDOM IN GULBURGA DISTRICT |
| |
|
5176 | Sameera P. |  | | PROBLEMS AND PROSPECTS OF KERALA STATE CIVIL SUPPLIES CORPORATION (SUPPLYCO) – A STUDY WITH SPECIAL REFERENCE TO THE MALAPPURAM DISTRICT |
| |
|
5175 | Javeria Khurshid |  | | IDENTITY ANALYSIS OF THE CONDEMNED AND THE FORBIDDEN IN “THE PEARL THAT BROKE ITS SHELL.” |
| |
|
5174 | Abdul Latif , Mohsin Hossain , Rashedul Alam Shipon and Redwanul Karim Fattah |  | | ADDITIONAL EARNING PRACTICES OF PROFESSIONALS BY USING IDLE CAPACITY: A STUDY ON TEACHERS’ EXTRA EARNING PRACTICES IN SYLHET CITY, BANGLADESH. |
| |
|
5173 | P. S. KAMBLE , G. P. PATIL |  | | NEGATIVE IMPACT OF PHATAKWADI DAM IN KOLHAPUR DISTRICT |
| |
|
5172 | V. B. Nagpure |  | | AGRICULTURAL DEVELOPMENTAND CHALLENGES IN INDIA |
| |
|
5170 | रेणु विहान |  | | मानवाधिकार और वर्तमान वैश्विक स्थिति |
| |
|
5169 | हरिणी रानी आगर |  | | हिन्दी उपन्यास में जनजातीय संस्कृति और लोक परम्परा |
| |
|
5167 | सी. आर. पालकर |  | | शल्य शास्त्रज्ञ – सुश्रुत |
| |
|
5166 | केशव अंबादास लहाने , विनोद बी. बोरसे |  | | छत्रपती शिवराय – एक लोककल्याणकारी व्यक्तीमत्व |
| |
|
5165 | Vijaykumar Kenchappa , A. G. Khan |  | | PREFARANCE TO CLINICAL DELIVERY IN INDIA: A CASE STUDY OF KARNATAKA |
| |
|
5164 | Sukdeo K. Thorat , Mukund S. Salunke |  | | THE EFFECTS OF USER GROUPS ON SWIMMING POOL WATER QUALITY |
| |
|
5163 | Seyed Saadat Masoumi , Shivaji Borhade |  | | IMPACT OF THE GLOBAL FINANCIAL CRISIS ON INDIAN ECONOMY |
| |
|
5162 | Golda Grace Duraisingh |  | | DEVELOPMENT OF SELF EMPLOYED WOMEN ENTREPRENEURS AS SOCIO-ECONOMIC CHANGE AGENTS IN TIRUNELVELI DISTRICT |
| |
|
5160 | M. K. Patil |  | | STATISTICAL ANALYSIS OF RAINFALL DATA OF SANGLI DISTRICT |
| |
|
5159 | D. R. Baad |  | | A STUDY OF RELATIONSHIP BETWEEN OCCUPATION OF THE WARKARIES (PILGRIMS) AND THEIR EXPENDITURE ON WARI ( YATRA ) IN PANDHARPUR |
| |
|
5158 | Rakesh Kumar Yadav , M. R. Augur |  | | ANALYSIS OF WATER QUALITY USING PHYSICO-CHEMICAL PARAMETERS OF MANIHARI RIVER IN TAKHATPUR, BILASPUR DISTRICT, CHHATTISGARH |
| |
|
5157 | N. S. Upadhyaya , Ashish Shrivastava |  | | A STUDY OF DEFINITIONS OF ENVIRONMENTAL PROTECTION AND HUMAN RIGHTS |
| |
|
5155 | L.Senthilkumar |  | | EMPLOYEE’S PERCEPTION REGARDING E-CHANNELS IN COMMERCIAL BANKS IN INDIA |
| |
|
5153 | Sujit Dhanraj Kumavat |  | | EFFECT OF YOGA PRACTICE ON STRESS AND ANXIETY AMONG YOGA PRACTICE PERSONS AND NON-YOGA PRACTICE PERSONS. |
| |
|
5152 | M. Vadivel , M. Palanisamy |  | | ECONOMIC ASSESSMENT OF OCCUPATION, EARNINGS AND HEALTH STATUS OF TEXTILE WORKERS IN COIMBATORE OF TAMIL NADU, INDIA |
| |
|
5151 | K. Mathivanan , S. Elumalai and G. Rajesh Kanna |  | | SCREENING, EXTRACTION AND ESTIMATION OF PHYCOBILIPROTEINS FROM CYANOBACTERIA |
| |
|
5139 | Vijay Kumar Grover |  | | RESEARCH APPROACH: AN OVERVIEW |
| |
|
5138 | Shiv Kumar , Krishna Kumar Pathak |  | | LEARNING DISABILITIES: A CHALLENGE TO EDUCATORS |
| |
|
5137 | Mohan Shakti |  | | ROLE OF PARLIAMENT TO STOP WATER POLLUTION AND ITS JUDICIAL ASPECTS IN INDIA |
| |
|
5136 | Ashok G. Jadhav |  | | STATUS OF WOMEN IN INDIA: ISSUES AND PROBLEMS |
| |
|
5131 | P. Naga Jyothi , M. Lavanya |  | | PUBLIC TRANSPORTATION SYSTEM MECHANISM WITH REFERNCE TO CITY OF HYDERABAD, TELANGANA |
| |
|
5130 | I. Ramesh , B. R. Kiran |  | | FISH DIVERSITY IN SHIVAJI TANK OF BHADRAVATHI TALUK, KARNATAKA |
| |
|
5129 | Deepti Chaurasia , Anjeev Kumar , Rakesh Kumar Shrivastava , Deepak Dubey and M. C. Songara | | | STUDY OF POST OPERATIVE WOUND INFECTIONS IN ATERTIARY CARE CENTRE |
| |
|
5128 | विजय कुमार |  | | ग्लोबल वार्मिंग : भौगोलिक विश्लेषण |
| |
|
5127 | Pawar R. M. , Patil R. R. |  | | CO-OPERATIVE SUGAR FACTORIES AND CHANGE IN THE METHODS OF FARMING IN SOLAPUR DISTRICT |
| |
|
5126 | Manjusha Mathapati |  | | ONLINE MARKETING: MARKET BUZZ TO SHOPPING EASE |
| |
|
5125 | Chidanand , Shivakumar S. Chengti |  | | MENTAL HEALTH AMONG CHRONIC PATIENTS |
| |
|
5124 | Ajay Kumar |  | | HANSI-A HISTORICAL TOWN (A BRIEF HISTORY OF HANSI REGION-EARLIEST TIMES TO 12TH C. A.D.) |
| |
|
5121 | Chanabasappa Sidramappa Mulage |  | | DEPICTION OF THE VIOLENT SIDE OF NATURE IN TED HUGHES’S HAWK ROOSTING AND PIKE |
| |
|
5120 | Sharad W. Akhand |  | | CMOS DESIGN OF TREE MULTIPLIER USING LOW POWER AND AREA EFFICIENT FULL ADDER |
| |
|
5118 | शकुन्तला जैन , प्रभावती कोठारी |  | | भारतीय महिलाएँ और घरेलू हिंसा |
| |
|
5117 | प्रशांत कोठे |  | | छत्रपती शिवाजी महाराज व संत तुकाराम महाराज यांच्यातील वैचारीक साम्य एक चिकित्सा |
| |
|
5116 | Vishal Subhash Bindwal |  | | A STUDY OF SELF-ESTEEM AND SELF CONCEPT OF HIGH AND LOW SOCIO-ECONOMIC STATUS OF COLLEGE STUDENTS HIGH AND LOW SOCIO-ECONOMIC STATUS OF COLLEGE STUDENTS |
| |
|
5114 | Kunal S. Badade , Jaideep Jadhav |  | | ANALYTICAL STUDY ON INVESTMENT STRATEGIES WITH SPECIAL REFERENCE TO GEN Y IN PUNE CITY |
| |
|
5113 | Deepak Sood , Navdeep Kaur |  | | IMPACT OF DEMOGRAPHIC FACTORS ON INVESTMENT RISK BEHAVIOUR OF INDIVIDUAL INVESTORS-A STUDY IN PUNJAB |
| |
|
5112 | Ramakrishna Mohan Rao Munaga |  | | THE IMPORTANCE OF PRODUCT POSITIONING AND WAYS TO POSITIONING THE BRAND |
| |
|
5111 | Omid Muhammad Zadeh , Somayeh Razavi Nia , Behrouz Sepid Nameh and Jalal Jafarpour |  | | ANTHROPOLOGICAL STUDY OF COMMON BELIEFS AND NOTIONS IN THE CULTURE OF PEOPLE OF CHARDAVAL IN ILAM(IRAN) PROVINCE |
| |
|
5110 | Sudhansu Kumar Dash |  | | DEVELOPING ENGLISH LANGUAGE SPEAKING CONFIDENCE: A CASE STUDY OF PRONUNCIATION AMONG STUDENTS OF ODISHA |
| |
|
5109 | Renuka S. G. |  | | VACHANA PHILOSOPHY DEPICTING HUMAN RIGHTS AND DUTIES |
| |
|
5107 | Jaysing M. Hotkar |  | | STRENGTH OF YOGA IN ACADEMIC DEVELOPMENT |
| |
|
5106 | Jayant J. Parmar |  | | SOCIAL ADJUSTMENT OF WORKING AND NON-WORKING WOMEN |
| |
|
5105 | B. Basavaraj , M. J. Basavaraj |  | | PERFORMANCE OF SELF HELP GROUPS IN INDIA: PARADIGM OF SUCCESS AND IMPEDIMENTS |
| |
|
5104 | A. Prabhakaran |  | | SOCIAL TRANSFORMATION IN TAMILNADU WITH SPECIAL REFERENCE TO CUDDALORE DISTRICT |
| |
|
5103 | पाडुरंग भिमराव बर्वे |  | | भारतीय राज्यघटनेतील कलम ३७० : एक अभ्यास |
| |
|
5098 | S. Saraswathi |  | | WOMEN’S EDUCATION IN TAMIL DISTRICTS OF THE MADRAS PRESIDENCY |
| |
|
5095 | Mohd Aarif Rather , Mohd Mansoor Beig |  | | INDIA’S MAJOR TRADE AND COMMERCE DURING THE MEDIEVAL PERIOD WITH ARABIAN COUNTRIES |
| |
|
5089 | Sanjay Prasad |  | | GLOBAL WARMING AND CLIMATE CHANGE |
| |
|
5087 | D. D. Pujari |  | | SIX SIGMA: NEED OF THE HOUR TO UNDERSTAND AND MANAGE CUSTOMER REQUIREMENTS FOR SUSTAINABLE DEVELOPMENT |
| |
|
5086 | S. Saminathan |  | | PERFORMANCE MANAGEMENT SYSTEM IN STATE BANK OF INDIA IN THANJAVUR DISTRICT OF TAMIL NADU |
| |
|
5067 | सुनील आखरे |  | | विदर्भाच्या तळेगांव – कोंढाळी पठारावरील आठवडी बाजार केंद्रांचे श्रेणीत्मक वर्गीकरण |
| |
|
5066 | K. Kamaraj , C. Kathiravan |  | | ENTREPRENEURIAL ENVIRONMENTS IN THE BUSINESS CITY OF SIVAKASI |
| |
|
5064 | Tathe S. V. |  | | INFANT MORTALITY IN MARTHWADA REGION A COMPARATIVE STUDY |
| |
|
5063 | S.Wilson , S. K. Sivasubramanian |  | | A STUDY ON SELF - CONCEPTAMONG HIGH SCHOOL STUDENTS |
| |
|
5062 | R. B. Patil |  | | EDUCATIONAL CHANGES AMONG REHABILITATED PEOPLE DISPLACED BY DUDHAGANGA IRRIGATION PROJECT (MH) |
| |
|
5061 | Mallikarjun J. Akki , Shivakumar S. Sangan |  | | WOMEN AND ENTREPRENEURSHIP IN INDIA: AN OVERVIEW |
| |
|
5060 | Devisri K. |  | | DEVELOPING AN EFFECTIVE CURRICULUM FOR GIFTED STUDENTS |
| |
|